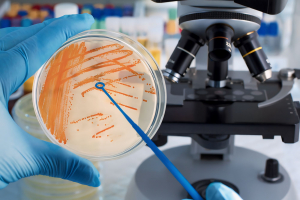

Detail Pengujian
Total Mikroba (ALT/TPC)
Deskripsi
Uji mikroba digunakan untuk mengetahui total mikroba dalam bahan pangan sebagai salah satu parameter standar mutu dan keamanan bahan pangan. Produk makanan yang aman dikonsumsi memiliki total mikroba di bawah angka maksimal mikroba bahan pangan sesuai SNI.
Syarat sampel yang diterima di Laboratorium Teknologi Pangan berupa cair, semi padat, dan padatan dengan jumlah minimal 10 gram.
Tarif Harga
| Jenis Pengujian | Kategori Ulangan | Harga |
|---|---|---|
| Internal | Duplo | Rp159.000,00/sampel |
| Triplo | Rp230.550,00/sampel | |
| Eksternal | Duplo | Rp198.750,00/sampel |
| Triplo | Rp248.437,00/sampel |